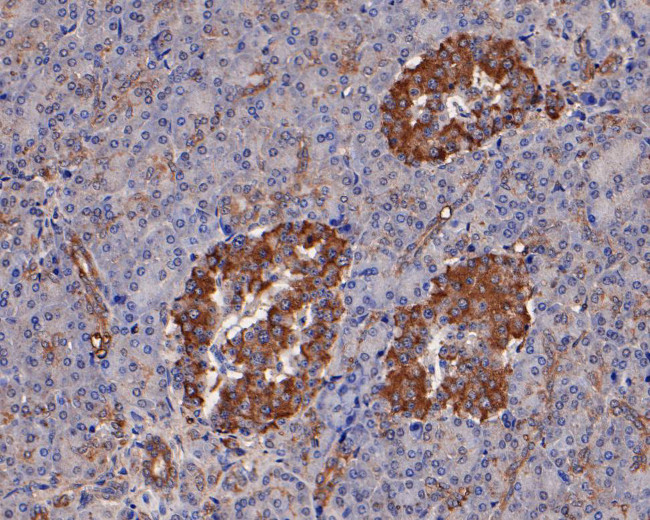
ATGL Antibody in Immunohistochemistry (Paraffin) (IHC (P))

Search
Invitrogen
ATGL Polyclonal Antibody
{{$productOrderCtrl.translations['antibody.pdp.commerceCard.promotion.promotions']}}
{{$productOrderCtrl.translations['antibody.pdp.commerceCard.promotion.viewpromo']}}
{{$productOrderCtrl.translations['antibody.pdp.commerceCard.promotion.promocode']}}: {{promo.promoCode}} {{promo.promoTitle}} {{promo.promoDescription}}. {{$productOrderCtrl.translations['antibody.pdp.commerceCard.promotion.learnmore']}}
图: 1 / 2
ATGL Antibody (PA5-119928) in IHC (P)


Please note: We are reviewing Western blot images included in the antibody testing data in our catalog, including those provided by third parties. Unless expressly labeled or annotated as “raw-unedited”, Western blot images included in the antibody testing data in our catalog may have been edited, optimized or otherwise adjusted for presentation.
产品信息
PA5-119928
种属反应
宿主/亚型
分类
类型
抗原
偶联物
形式
浓度
规格
纯化类型
保存液
内含物
保存条件
运输条件
RRID
产品详细信息
Positive Control: 293 cell lysate, HepG2 cell lysate, A431 cell lysate, human pancreas tissue.
Subcellular Location: Cell membrane, Lipid droplet.
靶标信息
Lipolytic enzymes are required for mobilization of fatty acids from triglyceride stores in adipose tissue. Energy homeostasis is affected by dysfunctional lipolysis and may contribute to the pathogenesis of obesity and insulin resistance. Until recently, hormone-sensitive lipase (HSL) was the only enzyme known to hydrolyze triglycerides in mammalian adipose tissue. It is now thought that a second enzyme, adipose triglyceride lipase (ATGL), catalyzes the initial step in triglyceride hydrolysis. ATGL is highly expressed in adipose tissue of mice and humans. It exhibits high substrate specificity for triacylglycerol and is associated with lipid droplets. Inhibition of ATGL markedly decreases total adipose acyl-hydrolase activity. Thus, ATGL and HSL coordinately catabolize stored triglycerides in adipose tissue of mammals.
仅用于科研。不用于诊断过程。未经明确授权不得转售。
篇参考文献 (0)
生物信息学
蛋白别名: Adipose triglyceride lipase; ATGL DESNUTRIN; Calcium-independent phospholipase A2-zeta; Desnutrin; DKFZp667M109; IPLA2 zeta; iPLA2-zeta; Patatin-like phospholipase domain-containing protein 2; PEDF R; PEDF-R; Pigment epithelium-derived factor receptor; plpl; plpl2; Transport-secretion protein 2; TTS 2.2; TTS2; TTS2.2
基因别名: ATGL; FP17548; PNPLA2
Entrez Gene ID: (Human) 57104